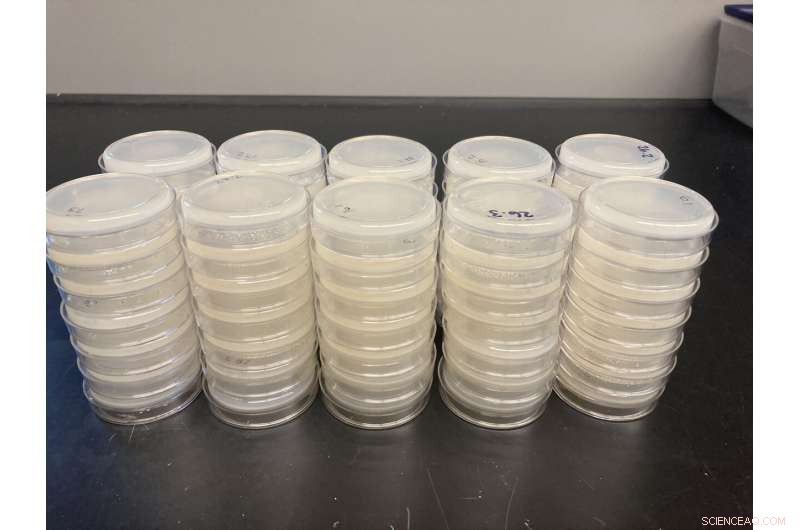
Virus Spillover Outcomes Vary Across Host Species

To study the outcomes of virus spillover, researchers placed small amounts of a virus onto petri-dish plates harboring populations of different Caenorhabditis species to see if the virus could replicate. Credit: David Kennedy, Penn State
Why has the SARS-CoV-2 virus ravaged the global human population, but many other animal viruses haven't? Using nematode worms as a model, researchers at Penn State conducted a set of experiments to investigate the factors influencing the disease outcomes of virus spillover events. They found that the species of the host influences whether a virus will take off in a new population. For example, some species never get infected, while others become infected and readily transmit the virus to other individuals within the species.
"Pathogens spill over into humans with somewhat alarming frequency, and a ton of terrific research has gone into determining where and when spillover is most likely," said David Kennedy, assistant professor of biology. "However, experimentally studying virus spillover in the lab to understand the likelihood that a virus will be transmissible in a new host is hugely challenging, especially with the replication needed to gain scientific insight."
Clara Shaw, a postdoctoral scholar at Penn State, who is starting a new position in January as an assistant professor at the University of Minnesota Duluth, noted that worms are a powerful experimental system.
"You can have an entire population of hosts in a single petri dish, and you can fit 50 replicate populations in a space the size of a shoebox," said Shaw. "This worm-virus system can allow for the careful study needed to inform which spillover events are likely to become the next COVID-19, and which ones are less concerning for human and animal health."
To conduct their study, which was published Sept. 21 in Proceedings of the Royal Society B, the researchers used species of nematode worms from the genus Caenorhabditis. One of these—Caenorhabditis elegans (C. elegans)—is commonly used in other types of biological experiments.
To first determine if the genus Caenorhabditis would be a useful system for studying the ecology and evolution of virus host jumps, the team examined the susceptibility of 44 species of Caenorhabditis to infection by the Orsay virus, a virus known to infect the well-studied C. elegans species, but not documented to occur in other species. They placed small amounts of the virus onto petri-dish plates harboring populations of different Caenorhabditis species to see if the virus could replicate. Of the 44 species tested, 14 species were susceptible to Orsay virus.
Clara Shaw, a postdoctoral scholar at Penn State, who is starting a new position in January as an assistant professor at the University of Minnesota Duluth, noted that worms are a powerful experimental system. "You can have an entire population of hosts in a single petri dish, and you can fit 50 replicate populations in a space the size of a shoebox," said Shaw. Credit: Clara Shaw, Penn State
Using these 14 species of susceptible worms, the team then assessed whether these species were capable of transmitting the virus by transplanting a subset of virus-exposed worms to virus-free habitat to reproduce and potentially transmit virus to offspring. This process was repeated to determine how long the virus was able to persist and whether it was able to persist indefinitely.
"We showed that in this one genus, different host species displayed the full range of possible outcomes following exposure to a novel pathogen," says Kennedy.
"Some never got infected; some got infected but were unable to transmit the virus; some got infected and transmitted the virus at levels so low that the pathogen ultimately died out; and some got infected and transmitted the virus well enough to maintain the virus indefinitely. This is the raw material needed to answer the question of why some spillover events lead to host jumps and new diseases while others just fizzle out on their own without any outside intervention."
Specifically, the team found that host species more closely related to C. elegans—the native host of the virus—were more susceptible to infection, and hosts that were closely related to each other had more similar susceptibilities regardless of their relationship to C. elegans.
"These patterns in susceptibility may be due to the fact that closely related hosts likely have similar receptors for virus attachment, similar within-host environments for viruses to navigate and similar defenses against viruses," says Shaw.
Kennedy noted that without a good model system to study virus spillover, it has been challenging to understand what factors facilitate new epidemics, and how evolution proceeds in emerging pathogens.
He says that "these worms can be used not only to probe how ecology impacts spillover and emergence, but also to better understand how and why spillover and emergence patterns may differ across hosts." + Explore further